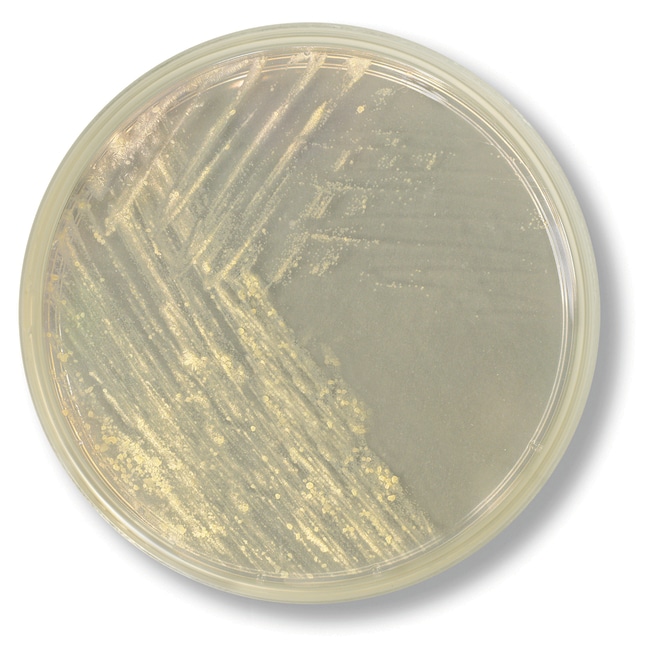

Search
Search
Isolate and cultivate Mycobacterium species from specimen containing mixed flora with this selective medium.
| Catalog Number | Quantity | Format |
|---|---|---|
| R08576 | 20/Pk. | F - slant |
| R01612 | 16/Pk. | 15mm x 60mm Plate |
| R01610 | 10/Pk. | Monoplate Deep Pour |
| R08574 | 100/Pk. | F - slant |
Isolate and cultivate Mycobacterium species from specimen containing mixed flora with Thermo Scientific™ Remel™ Mitchison 7H11 Selective Agar with Carbenicillin, Polymyxin B, Amphotericin B, and Trimethoprim. The presence of casein hydrolysate in the medium enhances growth of Mycobacterium species more than on Middlebrook 7H10. Different antibiotics act as selective agents against most Gram-positive and Gram-negative bacteria.
Mycobacteria are immobile, slow-growing, rod-shaped, gram-positive bacteria with high genomic content. The genus includes pathogens known to cause serious diseases in mammals, including tuberculosis and leprosy.
Mitchison 7H11 Selective Agar with Carbenicillin, Polymyxin B, Amphotericin B, Trimethoprim is a selective medium for isolation and cultivation of Mycobacterium species from specimens containing mixed flora.
Mitchison 7H11 Selective Agar contains inorganic salts which are essential to the growth of mycobacteria. Casein hydrolysate is a growth stimulant for drug-resistant strains of Mycobacterium tuberculosis. Glycerol is a source of carbon and energy. Sodium citrate is converted to citric acid which holds inorganic cations in sodium.
Not all products are available for sale in all territories. Please inquire.
Remel™ and Oxoid™ products are now part of the Thermo Scientific brand.
1. Middlebrook, G. and M.L.Cohn. 1985. Am. J. Public Health. 48:844-853.